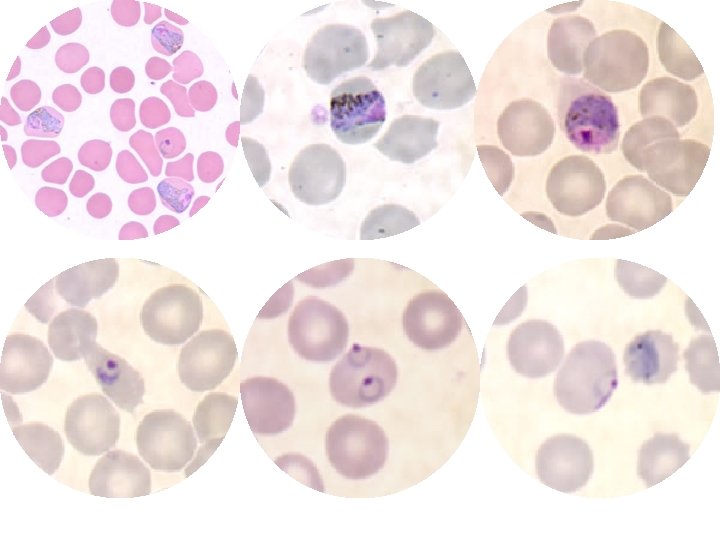

Malaria parasite Plasmodium vivax Plasmodium falciparum Plasmodium malariae

- Slides: 30
Malaria parasite Plasmodium vivax Plasmodium falciparum Plasmodium malariae Plasmodium ovale
Malaria parasites as a group (general information) * This parasite has the alternation of generations phenomena. That means the life cycle includes an asexual phase (schizogony) alternating with sexual one (gametogony) followed by (sporogony). * The malarial parasites require two hosts: 1. Vertebrate host, in which the asexual phase develops and gametocytes are produced. 2. Vector host (invertebrate host), in which the gametocytes become mature gametes.
Malaria parasites as a group (general information) * Following maturation, the microgamete unites with the macrogamete to form the zygote, which then become an oocyst which will produce the sporozoites later. * When the numerous sporozoites are introduced into the vertebrate host, they will develop into the asexual stage.
Malaria parasites as a group (general information) * There are two separate transfer stages, the gametocyte and the sporozoites. * The asexual phase or cycle called (schizogony) and is found only in the vertebrate host, while maturation and union of sex cells followed by production of sporozoites take place only in blood sucking invertebrates, mostly arthropods and predominantly mosquitoes.
The factors influencing the effectiveness of a particular species of Anopheles in transmission of malaria are: 1. Susceptibility to infection by the parasite. 2. Survival long enough for development and transmission of the sporozoites. 3. A preference for human blood. 4. Presence in sufficient numbers.
Life cycle 1. Schizogony (in the human): A. Pre-erythrocytic development (Asexual Development out of the R. B. Cs. ): * Inoculation occurs when an infected female Anopheles mosquito injects saliva containing sporozoites into cutaneous blood vessels in a preparation to take a blood meal. The insect injects spindle shape bodies (the sporozoites) which circulate in the blood stream, but within a half an hour they will disappear.
Life cycle * The first colonization takes place in the parenchymal cells of the liver where the sporozoites will pass through two schizogony, the first called (primary exoerythrocytic schizogony) the second one called (secondary exoerythrocytic schizogony) except in Plasmodium falciparum where the parasite passingle schizogony in the liver.
Life cycle * The first generation called (cryptozoites) and sometimes called (merozoites), while the second generation individuals called (metacryptozoites), after (7 -10) days in the liver the parasite enters the R. B. Cs. * The first evidence of infection can be seen (48 hours) to (7 days) later in the parenchymal cells of the liver, where young schizonts in active nuclear division observes, these are termed primary exoerythrocytic (EE) schizonts or pre-erythrocytic schizonts.
Life cycle * The average incubation period, is (12) days for P. falciparum, (13) to (17) days for P. vivax and P. ovale and (28 to 30) days for P. malariae. * The incubation period: is the time between the inoculation of sporozoites and the first appearance of clinical sings, of which fever is the most common.
Life cycle B. Erythrocytic development: (Asexual Development in R. B. Cs. ): * When the merozoites which have developed in the preerythrocytic foci enters the red blood cells, they transform into trophozoites, which grow and develop into schizonts, each producing the number of merozoites characteristic of the species of Plasmodium. When fully matured, the merozoites break out of the parasitized R. B. C. and soon actively enter other R. B. Cs. to repeat the asexual cycle.
Life cycle * The merozoites that enters the R. B. Cs. appears in the beginning in a ring phase called (ring stage) because of the presence of a vacuole or space in the middle of the parasite surrounded by a ring of cytoplasm and a minute nucleus in one side. * when it is grow because of its feeding on the R. B. Cs. Content, it is become rounded then irregular so called (amoeboid shape trophozoite) which is produce the schizont stage then. * in the case of P. falciparum the R. B. C. become more viscous, so it aggregates in the internal organs and not appear in circulation. (Important)
Life cycle * The infected R. B. Cs. with P. vivax, after the appearance of the ring stage it characterized by the appearance of minute dots stains with red color or (reddish-orange) in Giemsa or right stained thin blood films called (Schüffner’s dots) or granules, also the R. B. C. appears swelling and paler; however, this dots appears also in the case of P. ovale, but in this case the infected R. B. C. becomes oval in shape (the cause of the name). In the case of P. falciparum appears reddish dots called (Maurer’s dots) this dots less in number and larger than the first type. In P. malariae appears other dots called (Ziemann’s dots).
Life cycle * After the destruction of the R. B. Cs. the dots, many material & wastes which produced by the parasites will be freeing to the blood stream, when it reaches to the spleen & other organs, sometimes under the skin, the infected person feels with chills or shivering then fever then sweating sequently. * The merozoites spend a regular period from the entrance to the growing & forming new merozoites, these periods are:
Life cycle (48)hr. in P. vivax & P. ovale (72)hr. in P. malariae (36 -48)hr. in P. falciparum. * After many generations of schizont stage, some of the merozoites grow slowly and form more pigments and each one grow to gametocyte. * There are two type of gametocyte microgametocyte (♂) & macrogametocyte (♀). These gametocytes will continue in the circulation for many weeks, but it isn’t growing in the human body.
* It is important to note that these gametocytes are crescent in case of P. falciparum while they are rounded in the other types.
Life cycle 2. Gametogony (in the mosquito): * Once the ripe gametocytes are ingested by female Anopheles mosquitoes with the blood meal and reach the midgut, they transform into mature gametes. * One macrogametocyte develops a single macrogamete (unfertilized oocyst or ovum), and one microgametocyte produces several flagellated microgametes. * A microgamete then enters a macrogamete, resulting in a zygote which become a motile Ookinete, migrates through the stomach wall and becomes an oocyst just under the outer membrane of the stomach.
Life cycle * The oocyst grows rapidly and develops internal nuclear centers, each center then produces a large number of delicate, spindle-shaped sporozoites. By time the sporozoites become mature, the wall of the greatly enlarged oocyst bursts, releasing the sporozoites in to the hemocoele of the mosquito.
Life cycle * The sporozoites then migrate to the salivary glands, and from there they pass down through the salivary ducts into the median tube (hypopharyngeal tube) of the mosquito proboscis. When the mosquito take its next blood meal, the sporozoites are injected into the cutaneous blood vessels of the victim and initiate a new infection.
Symptomatology * The incubation period extends from many weeks to months until the symptoms appear, which is sequent paroxysm in regular periods of shivering or chill then fever then sweating. * Other important symptoms characterized by splenomegaly and hepatomegaly, and increase in the bone marrow activity. * There is also secondary sings like constipation, diarrhea and anemia (pernicious anemia).
Symptomatology * Sometimes relapses occurs, after the disappearance of the symptoms, when the immune system become non-efficient; whenever, the symptoms of the infection appears without new exposure for mosquito bite, the cause of that is some hidden stages in the liver cells.
Diagnosis By making (blood films): 1. Thick blood films: are frequently necessary to detect the parasites. This type allows rapid examination of a large volume of blood in a small area on the slide. Staining of thick blood films is carried out according to Giemsa technique. These films provide a concentration of the parasites. 2. Thin blood films: it is also essential that thin films be prepared because the malarial species can be more readily identified on these, especially less experienced examiners. It is stain by Giemsa stain or Right stain.
Treatment * All malaria infection except resistant P. falciparum: Chloroquine diphosphate (orally). * Treatment of attack: If oral dose can’t be given, Quinine dihydrochloride (IV), Chloroquine hydrochloride (IM).
Table show “Comparison between the 4 species of Plasmodium” Distinctive character The infective R. B. Cs. size The infective R. B. Cs. color The infective R. B. Cs. shape The pigment dots The lasting of schizogony in blood Names Percentage of infection/total Spreading P. vivax P. ovale P. malariae P. falciparum Enlargement Slight enlargement Pale No enlargement Normal Ovale, may be fimbriated Schüffner’s dots 48 hrs. Ovale Circular, but may be crenated Maurer’s dots 36 -48 hrs. Benign malaria Simple malaria Tertian malaria 43% Ovale tertian malaria Quartan ague Rare 7% Tropical & temperate climates Rarely spreaded Tropical & temperate climates Become pale Circular as it is Schüffner’s dots 48 hrs. Ziemann’s dots 72 hrs. Malignant malaria Aestivo-autumnal malaria 50% Tropical & subtropical, but are not spreaded northward as it is in P. vivax